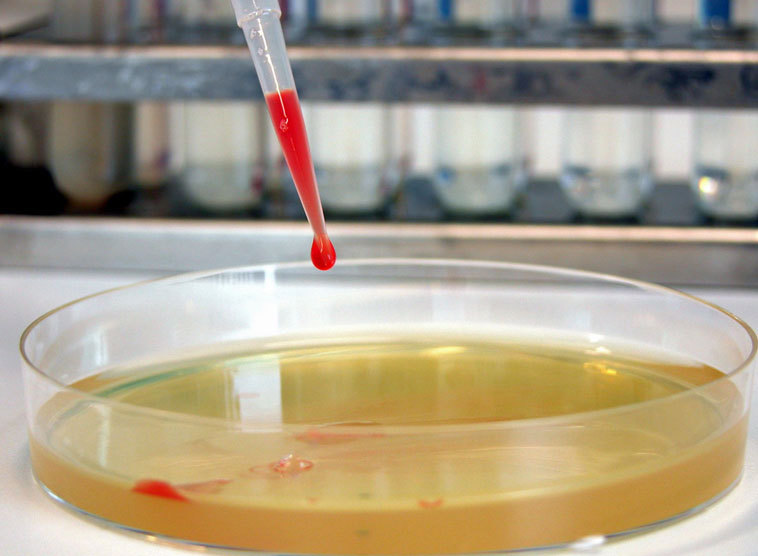
Labor

Betreiber von Kinderwunschkliniken fordern bereits jetzt eine Liberalisierung des Gesetzes. "Was wir brauchen, ist nicht eine weitere Liberalisierung, sondern Transparenz und Sicherheit für alle Betroffenen", so Schaffelhofer.
Fortpflanzungsmedizin: Katholische Aktion fordert Nachbesserungen
KAÖ-Präsidentin Schaffelhofer: "Gesetz rasch evaluieren und nachbessern". Einschränkungen bei der Eizellspende werden "systematisch umgangen". Förderung unabhängiger Beratung, Dokumentation und zentrales Register nötig.
Eine rasche Evaluierung und Nachbesserung des Fortpflanzungsmedizingesetzes und dessen Umsetzung hat die Katholischen Aktion Österreich (KAÖ) gefordert. Schon wenige Monate nach Inkrafttreten des Gesetzes am 23. Februar zeigten sich heute "einige jener Auswirkungen, vor denen wir eindringlich gewarnt haben", erklärte KAÖ-Präsidentin Gerda Schaffelhofer am Montag, 15. Juni 2015, in einer Aussendung. Von den zuständigen Ministerien für Gesundheit, Justiz und Familie erwarte sie "Auskunft darüber, wie sie auf die Fehlentwicklungen und die Umgehung des Gesetzes reagieren werden".
Nachfrage größer als das Angebot
Schaffelhofer verwies auf einen Bericht der Wochenzeitung "Die Furche" und auf Informationen, die Fortpflanzungsmediziner in der Vorwoche selbst öffentlich gemacht hatten. Seit Zulassung der Eizellenspende per Gesetzesänderung gebe es demnach einen regelrechten Zustrom von Paaren aus Deutschland und auch anderen europäischen Ländern. Die Nachfrage nach Spendereizellen sei damit größer als das Angebot.
Das neue Gesetz untersagt die entgeltliche Überlassung sowie die Vermittlung von entwicklungsfähigen Zellen, von Samen und Eizellen und von Spenderpersonen, sowie auch jede Werbung dafür. "Dieses Verbot wird bereits auf vielfache Weise unterlaufen, und Fortpflanzungsmediziner geben das auch öffentlich zu", so Schaffelhofer. Sie kritisierte zudem die fehlenden Angaben im Gesetzestext darüber, wie dieses Verbot kontrolliert werden soll. Die dafür zuständige Gesundheitsministerin habe sich dazu bisher nicht geäußert, "auch nicht auf ausdrückliche briefliche Nachfrage der Plattform www.kinderbekommen.at Ende April", betonte die KAÖ-Präsidentin.
Ausbeutung von Frauen wird verschwiegen
Empört zeigte sich Schaffelhofer besonders darüber, "dass die Eizellenspende nach wie vor als ein für die Spenderin harmloser medizinischer Eingriff hingestellt wird". Verschwiegen werde dabei, dass die Methode zu enormen Belastungen für die Spenderin führe. Durch die Hormonstimulation werde zudem auch der Eizellpool stark reduziert, was sich zumindest langfristig negativ auf die Fruchtbarkeit der Spenderin auswirkt, verwies die KAÖ-Präsidentin auf Aussagen u.a. des Wiener Gynäkologen Johannes Huber. Eine "pure Ausbeutung von Frauen" geschehe hier, zu der die Frauenrechtlerinnen jedoch schwiegen. Schaffelhofer: "Wenn es um den eigenen Bauch geht, zählt der Bauch von anderen Frauen plötzlich gar nichts mehr?"
Unabhängige Beratung über IVF-Fonds ermöglichen
Als "zweites großes Manko" des Fortpflanzungsmedizingesetzes zeige sich weiters die fehlende Verpflichtung zu unabhängiger Beratung, und zwar sowohl bei künstlicher Befruchtung als auch bei Eizellenspenden, führte die Präsidentin der Katholischen Aktion weiter aus. Dass damit dem Arzt, der den Eingriff durchführt und damit sein Geld verdient, auch die Beratung überlassen ist - er muss gegenüber seinen Patientinnen lediglich auf die Möglichkeiten unabhängiger Beratung hinweisen - sei ein "untragbarer und fahrlässiger" Interessenskonflikt, den der Gesetzgeber trotz zahlreicher Kritik im Vorfeld nicht geregelt habe.
Schaffelhofers Forderung: Die Gesundheits- und die Familienministerin sollten durch eine gemeinsame Verordnung die unabhängigen Beratungsleistungen durch Mittel des IVF-Fonds fördern. Damit könnten diese Leistungen allen unmittelbar Betroffen von Maßnahmen künstlicher Fortpflanzung - Eltern, Samenspender und Eizellenspenderinnen sowie Kinder - zugänglich gemacht werden, auch unabhängig von derer jeweils eigenen finanziellen Situation.
Zentrales Register notwendig
Die KAÖ-Präsidentin bekräftigte weiters die Forderung nach einem zentralen Register über Samen- und Eizellspende, um eine vereinfachte Auskunftsmöglichkeit der Kinder über ihre genetischen Eltern sicherzustellen. Derzeit sind Gesundheits- und Justizminister beauftragt, die Möglichkeit der Schaffung eines solchen Registers zu prüfen - dies auch, um andere Vorgaben des Fortpflanzungsmedizingesetzes zu erfüllen. So dürfen dritte Personen ihren Samen bzw. ihre Eizellen stets nur derselben Krankenanstalt zur Verfügung stellen, auch dürfen Samen bzw. Eizellen dritter Personen für die künstliche Befruchtung bei höchstens drei unterschiedlichen Paaren verwendet werden. "Zwar ist ein Zuwiderhandeln mit Strafen belegt, ohne zentrales Register kann die Einhaltung des Gesetzes aber kaum überprüft werden, die Regelung wäre somit zahnlos", hält Schaffelhofer fest.
Die Einführung einer umfassenden mittel- und langfristigen Dokumentation sowie die Erforschung der Auswirkungen der Maßnahmen künstlicher Fortpflanzung würden im neuen Fortpflanzungsmedizingesetz völlig fehlen, so Schaffelhofer. Davon seien in medizinischer Hinsicht die Mütter, die das Kind ausgetragen haben, sowie die Eizellspenderinnen und die Kinder selbst betroffen. In psychologischer Hinsicht wären in eine mittel- und langfristige Forschung jedoch auch alle anderen unmittelbar Beteiligten wie etwa Partner und Samenspender einzubeziehen.
In anderen Ländern werden solche Maßnahmen zur langfristigen Qualitätssicherung in dem Bereich bereits seit längerem vorgeschrieben und finanziert. "Es ist nicht einsichtig, warum in Österreich darauf bewusst verzichtet wird", so Schaffelhofer. Der Entschließungsantrag zur Gesetzesnovelle hat das Gesundheitsministerium beauftragt zu prüfen, welche Daten zur Gewährleistung der Qualitätssicherung der medizinisch unterstützten Fortpflanzung erhoben werden sollen. Die Prüfergebnisse sollen möglichst innerhalb von zwei Jahren vorliegen, wobei Schaffelhofer auf "möglichst rasche" Ergebnisse hoffte.
Warnung vor Leihmutterschaft
Betreiber von Kinderwunschkliniken fordern bereits jetzt eine Liberalisierung des Gesetzes. "Was wir brauchen, ist nicht eine weitere Liberalisierung, sondern Transparenz und Sicherheit für alle Betroffenen", so Schaffelhofer dazu. Sie bekräftigte in diesem Zusammenhang auch das klares Nein der Katholischen Aktion zur Leihmutterschaft, die international immer mehr zum Problem werde.
Plattform www.kinderbekommen.at
Bürgerinitiative für die anonyme Erhebung von Zahlen und Motiven zu Schwangerschaftsabbrüchen: www.fakten-helfen.at




































































































